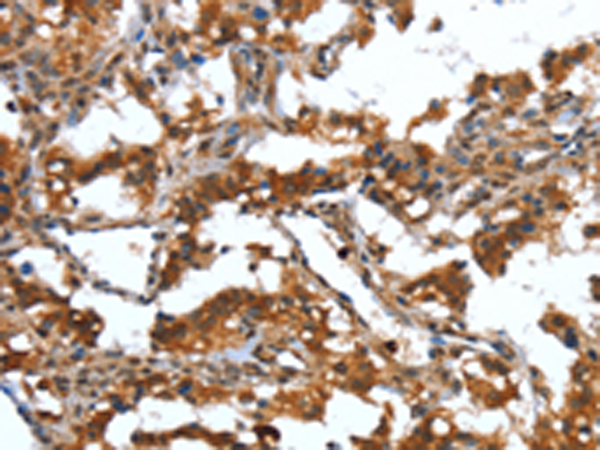
一抗

|
Background: |
Defensins are a family of microbicidal and cytotoxic peptides thought to be involved in host defense. They are abundant in the granules of neutrophils and also found in the epithelia of mucosal surfaces such as those of the intestine, respiratory tract, urinary tract, and vagina. Members of the defensin family are highly similar in protein sequence and distinguished by a conserved cysteine motif. Several alpha defensin genes are clustered on chromosome 8. This gene differs from other genes of this family by an extra 83-base segment that is apparently the result of a recent duplication within the coding region. The protein encoded by this gene, defensin, alpha 4, is found in the neutrophils; it exhibits corticostatic activity and inhibits corticotropin stimulated corticosterone production. |
|
Applications: |
ELISA, IHC |
|
Name of antibody: |
DEFA4 |
|
Immunogen: |
Synthetic peptide of human DEFA4 |
|
Full name: |
defensin, alpha 4, corticostatin |
|
Synonyms: |
HP4; DEF4; HP-4; HNP-4 |
|
SwissProt: |
P12838 |
|
ELISA Recommended dilution: |
2000-5000 |
|
IHC positive control: |
Human thyroid cancer and Human brain |
|
IHC Recommend dilution: |
50-200 |

 購物車
購物車 幫助
幫助
 021-54845833/15800441009
021-54845833/15800441009